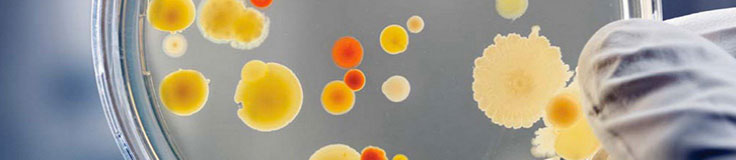
The Potential of Bone Marrow Mononuclear Cells & stem cells

Primary Cells
-
Posted: April 06, 2026Read more »
Genome-wide association studies (GWAS) have identified key genetic risk loci for non-alcoholic fatty liver disease (NAFLD), metabolic dysfunction–associated steatohepatitis (MASH), liver fibrosis, and hepatocellular carcinoma (HCC) with high precision. Working directly in primary human hepatocytes and
-
Posted: February 03, 2026Read more »Heart Health in Focus: Cardiac Primary Cells for Cardiovascular DiscoveryFebruary marks American Heart Month, an observance dedicated to advancing awareness of cardiovascular health and the critical research needed to prevent and treat heart disease. At ScienCell, we recognize the essential role that
-
Posted: October 07, 2025Read more »
Neurons are the dynamic, anatomically, functionally, and trophically vital units of the brain, responsible for electrochemically transmitting information across the nervous system. While all neurons share common morphological features, their regional specialization is what truly drives brain function.
-
Posted: June 10, 2025Read more »
Unlocking the full potential of human pluripotent stem cells (hPSCs) often hinges on effective cryopreservation techniques.
ScienCell provides StemCryo®, a cutting-edge solution designed to ensure the viability and pluripotency of these invaluable cells for your critical research.
-
Posted: June 09, 2025Read more »
Fibroblasts, fundamental mesenchymal cells derived from the embryonic mesoderm, are widely utilized in cellular and molecular research due to their ease of culture and robust nature. These versatile cells are key secretors of a non-rigid extracellular matrix, abundant in type I and/or type III collagen,
-
Posted: May 28, 2025Read more »
Macrophages are crucial cells in the body, known for their role in removing cellular debris and destroying invading pathogens. Their main functions include phagocytizing invading microorganisms and scavenging dead, damaged cells, and cellular debris.
Given their primary functions involving phagocytosis,
-
Posted: May 21, 2025Read more »
Astrocytes are the most abundant cell type in the central nervous system (CNS). They serve a variety of vital functions including supporting neuronal transmission and survival, regulating the blood-brain barrier, contributing to anti-inflammatory responses, and aiding in wound repair.
Astrocytes also
-
Posted: May 18, 2025Read more »
Hepatic stellate cells (HSteC) are essential intralobular connective tissue cells that perform diverse functions in the liver, including extracellular matrix homeostasis, repair, regeneration, fibrosis, and control of retinol metabolism, storage, and release. HSteC are a powerful model for studying liver
-
Posted: May 08, 2025Read more »
As the demand for advanced models in regenerative medicine and hair restoration therapies grows, so does the need for reliable, physiologically relevant primary cells.
ScienCell Research Laboratories offers a suite of human hair follicle cell types to empower your research — each isolated from human
-
Posted: May 01, 2025Read more »
ScienCell Research Laboratories offers a robust foundation for skeletal muscle research with our high-purity Human Skeletal Muscle Cells (HSkMC, Cat. #3500). These cells are isolated from adult human skeletal muscle and cryopreserved at passage one to ensure optimal viability and physiological relevance. -
Posted: April 30, 2025Read more »
Dermal fibroblasts, derived from the embryonic mesoderm are fundamental components of the skin's dermis layer. Their versatility and ease of culture make them extensively used in cellular and molecular studies. Due to their durability, they are also suitable for a variety of manipulations, such as gene
-
Posted: April 08, 2025Read more »Hepatic stellate cells (HSCs) are essential to liver function, playing a central role in homeostasis, extracellular matrix maintenance, repair, and regeneration. ScienCell Research Laboratories provides high-quality primary human hepatic stellate cells (HHSteC) to support cutting-edge research into liver
-
Posted: December 10, 2024Read more »
The central nervous system (CNS) is a complex network of neurons and glia that play critical roles in human brain function. Neurons are the primary signaling units of the nervous system, responsible for transmitting information throughout the body.
- A single neuron can contact up to 10,000 other neurons,
-
Posted: January 02, 2024Categories: Primary CellsRead more »
The ocular lens is a transparent structure in the eye that is designed to refract and focus light onto the retina. The lens is an avascular unit which includes the lens capsule, lens epithelium, and lens fibers. Lens fiber cells form the bulk of the lens and a monolayer of epithelial cells cover the
-
Posted: September 28, 2020Categories: Primary CellsRead more »
Microglia play an essential role in brain homeostasis, neuroinflammation, neurodegenerative diseases, and brain infections. Microglia are integral components of the neuro-glial cell network and are the resident immune cells of the brain. Recent studies indicate that microglia are derived from the yolk
-
Posted: April 30, 2020Read more »
Hepatic sinusoidal endothelial cells (HSEC) are fascinating cells that are uniquely adapted to their location in the liver. HSEC are found lining micro-vessels in the liver and are extremely specialized endothelial cells. Structurally and functionally they have distinctive features which include: open
-
Posted: April 03, 2020Read more »
Epithelial cells are the most numerous cells in the lungs and contribute to innate and adaptive immunity. Airway epithelial cells are located in the lower respiratory tract which includes the trachea, bronchi, small airways (bronchioles), and alveoli. Due to their location, airway epithelial cells are
-
Posted: September 05, 2019Categories: Primary CellsRead more »
Migraines and headaches can be extremely debilitating with a diverse set of triggers and symptoms. Although the pathophysiology for headaches is still unclear, evidence suggests that factors such as neurogenic inflammation and meningeal sensory innervation play important roles in the development of
-
Posted: July 22, 2019Comments: 2Read more »
Traditional 2D cultures have been used widely over the past decades to study cell biology, molecular biology and conduct translation research such as drug discovery. Cells in 2D culture, however, are forced to adopt a planar morphology and maintain cellular interactions only in lateral directions, altering
-
Posted: June 09, 2019Read more »
Hepatic stellate cells have recently gained a great deal of attention regarding their contribution to the progression of diseases such as liver fibrosis, non-alcoholic steatohepatitis (NASH), and hepatocellular carcinoma. They are mesenchymal cells that are located between sinusoidal endothelial cells
-
Posted: May 30, 2018Read more »
When working with primary cells, it is important to remember that they are not cell lines and should be treated with care. At ScienCell, we specialize in primary cell culture and we are very familiar with the common problems researchers encounter when culturing them. We have compiled a list with 13
-
Posted: March 13, 2018Read more »Mesenchymal Stem Cell Medium-animal component free (Cat. #7521)
For decades, Fetal Bovine Serum (FBS) has been a vital supplement for the successful culture of a diverse range of cell types. FBS is an undefined, complex source of growth factors, hormones, lipids, attachment factors, and trace elements.
-
Posted: November 29, 2017Read more »
Primary cells, which are isolated directly from tissue, show normal cell morphology and maintain many of the important markers and functions seen in vivo. Primary cells, though, have a finite lifespan and limited expansion capacity, so it is critical to use low passage primary cells for your research.
-
Posted: October 24, 2017Comments: 3Read more »
Neuronal cell lines are commonly used for in vitro neurobiology studies because they are more easily transfected compared to primary neurons and they proliferate, whereas primary neurons do not. Neuronal cell lines can be induced to differentiate into neuron-like cells, where they express neuronal markers
-
Posted: October 22, 2017Comments: 2Read more »
The 2017 Nobel Prize in Physiology or Medicine was awarded to Jeffrey C Hall, Michael Rosbash, and Michael W Young for research that established key mechanistic principles on how circadian rhythms are regulated. Circadian rhythms are endogenous oscillations adjusted to changing external cues and driven
-
Posted: March 26, 2017Categories: Company, Information, Gene Expression Profiling, Cell Culture Media, Primary Cells, Cell Based Assays, News
-
Posted: February 14, 2017Read more »
CARLSBAD, Calif. -- ScienCell Research Laboratories, Inc. is a unique supplier of primary Human Schwann Cells to the scientific research community. Schwann cells are glial cells that protect and insulate nerves in the peripheral nervous system.
"There are numerous cell types, such as Schwann cells,
-
Posted: October 26, 2016Categories: Primary CellsRead more »
ScienCell's Rat Hippocampal Neurons Used in Recent Neurological Disease Therapy Research Published in Scientific Reports Journal
Neurons are dynamically polarized cells responsible for electrochemically transmitting information throughout the nervous system. Scientists have characterized
-
Posted: September 28, 2016Categories: Primary CellsRead more »
ScienCell's Mouse Microglia Used in Recent Microglial Activation Research Published in Molecular & Cellular Proteomics Journal
Microglia are a type of macrophage-like glial cell in the central nervous system (CNS) and they function as the brain's primary immune defenders. Upon activation,
-
Read more »
When it comes to primary cell culture, a picture is worth a thousand words. A quality image can convey information on cell morphology, health, culture purity and density. Different types of 2-dimensional microscopy techniques such as phase contrast, relief contrast, and fluorescence microcopy can
-
Posted: August 17, 2016Read more »
After watching displays of astounding athletic prowess in the 2016 Olympics, I was inspired to take a closer look at the science behind exercise training, recovery, and injury with a focus on the importance of blood vessels during exercise.
Let’s start with some basic training: Why are blood vessels
-
Posted: August 01, 2016Categories: Primary CellsRead more »
Many primary cells have difficulty adhering to uncoated glass and plastic surfaces, especially in low serum or serum-free conditions. For primary cells, it is necessary to use a substrate coating to enhance cell attachment. There are many different substrates to choose from and each type can have dramatically
-
Read more »
Recently, bone marrow mononuclear cells (BMMC) have been in the spotlight for having the potential to treat a variety of diseases including neurological disorders. Why are BMMC so exciting and do they really show treatment potential? BMMC have regenerative capabilities and are a heterogeneous population
-
Posted: January 21, 2016Categories: Primary CellsRead more »
Cell culture studies provide a valuable complement to in vivo experiments, allowing for a more controlled manipulation of cellular functions and processes. For decades, cell lines have played a critical role in scientific advancements, yet researchers have become increasingly cautious when interpreting
-
Read more »
When working with primary cells, it is important to remember that they are not cell lines and cannot be treated the same. Because ScienCell has extensively working with primary cells, we are very familiar with the common problems researchers encounter when culturing them. Here are six common mistakes
-
Posted: December 27, 2015Categories: Primary CellsRead more »
CD-1 IGS mice are outbred mice derived from a group of outbred Swiss mice developed at the Anti-Cancer Center in Lausanne, Switzerland. They were imported to the US in 1926 and to Charles River in 1959. The CD-1 IGS mice are generally used for genetics, toxicology, pharmacology, and aging research.
-
Read more »
Cell culture studies provide a valuable complement to in vivo experiments, allowing for a more controlled manipulation of cellular functions and processes. For decades, cell lines have played a critical role in scientific advancements, yet researchers have become increasingly cautious when interpreting






.png)

.jpg)
.jpg)
.jpg)
.jpg)